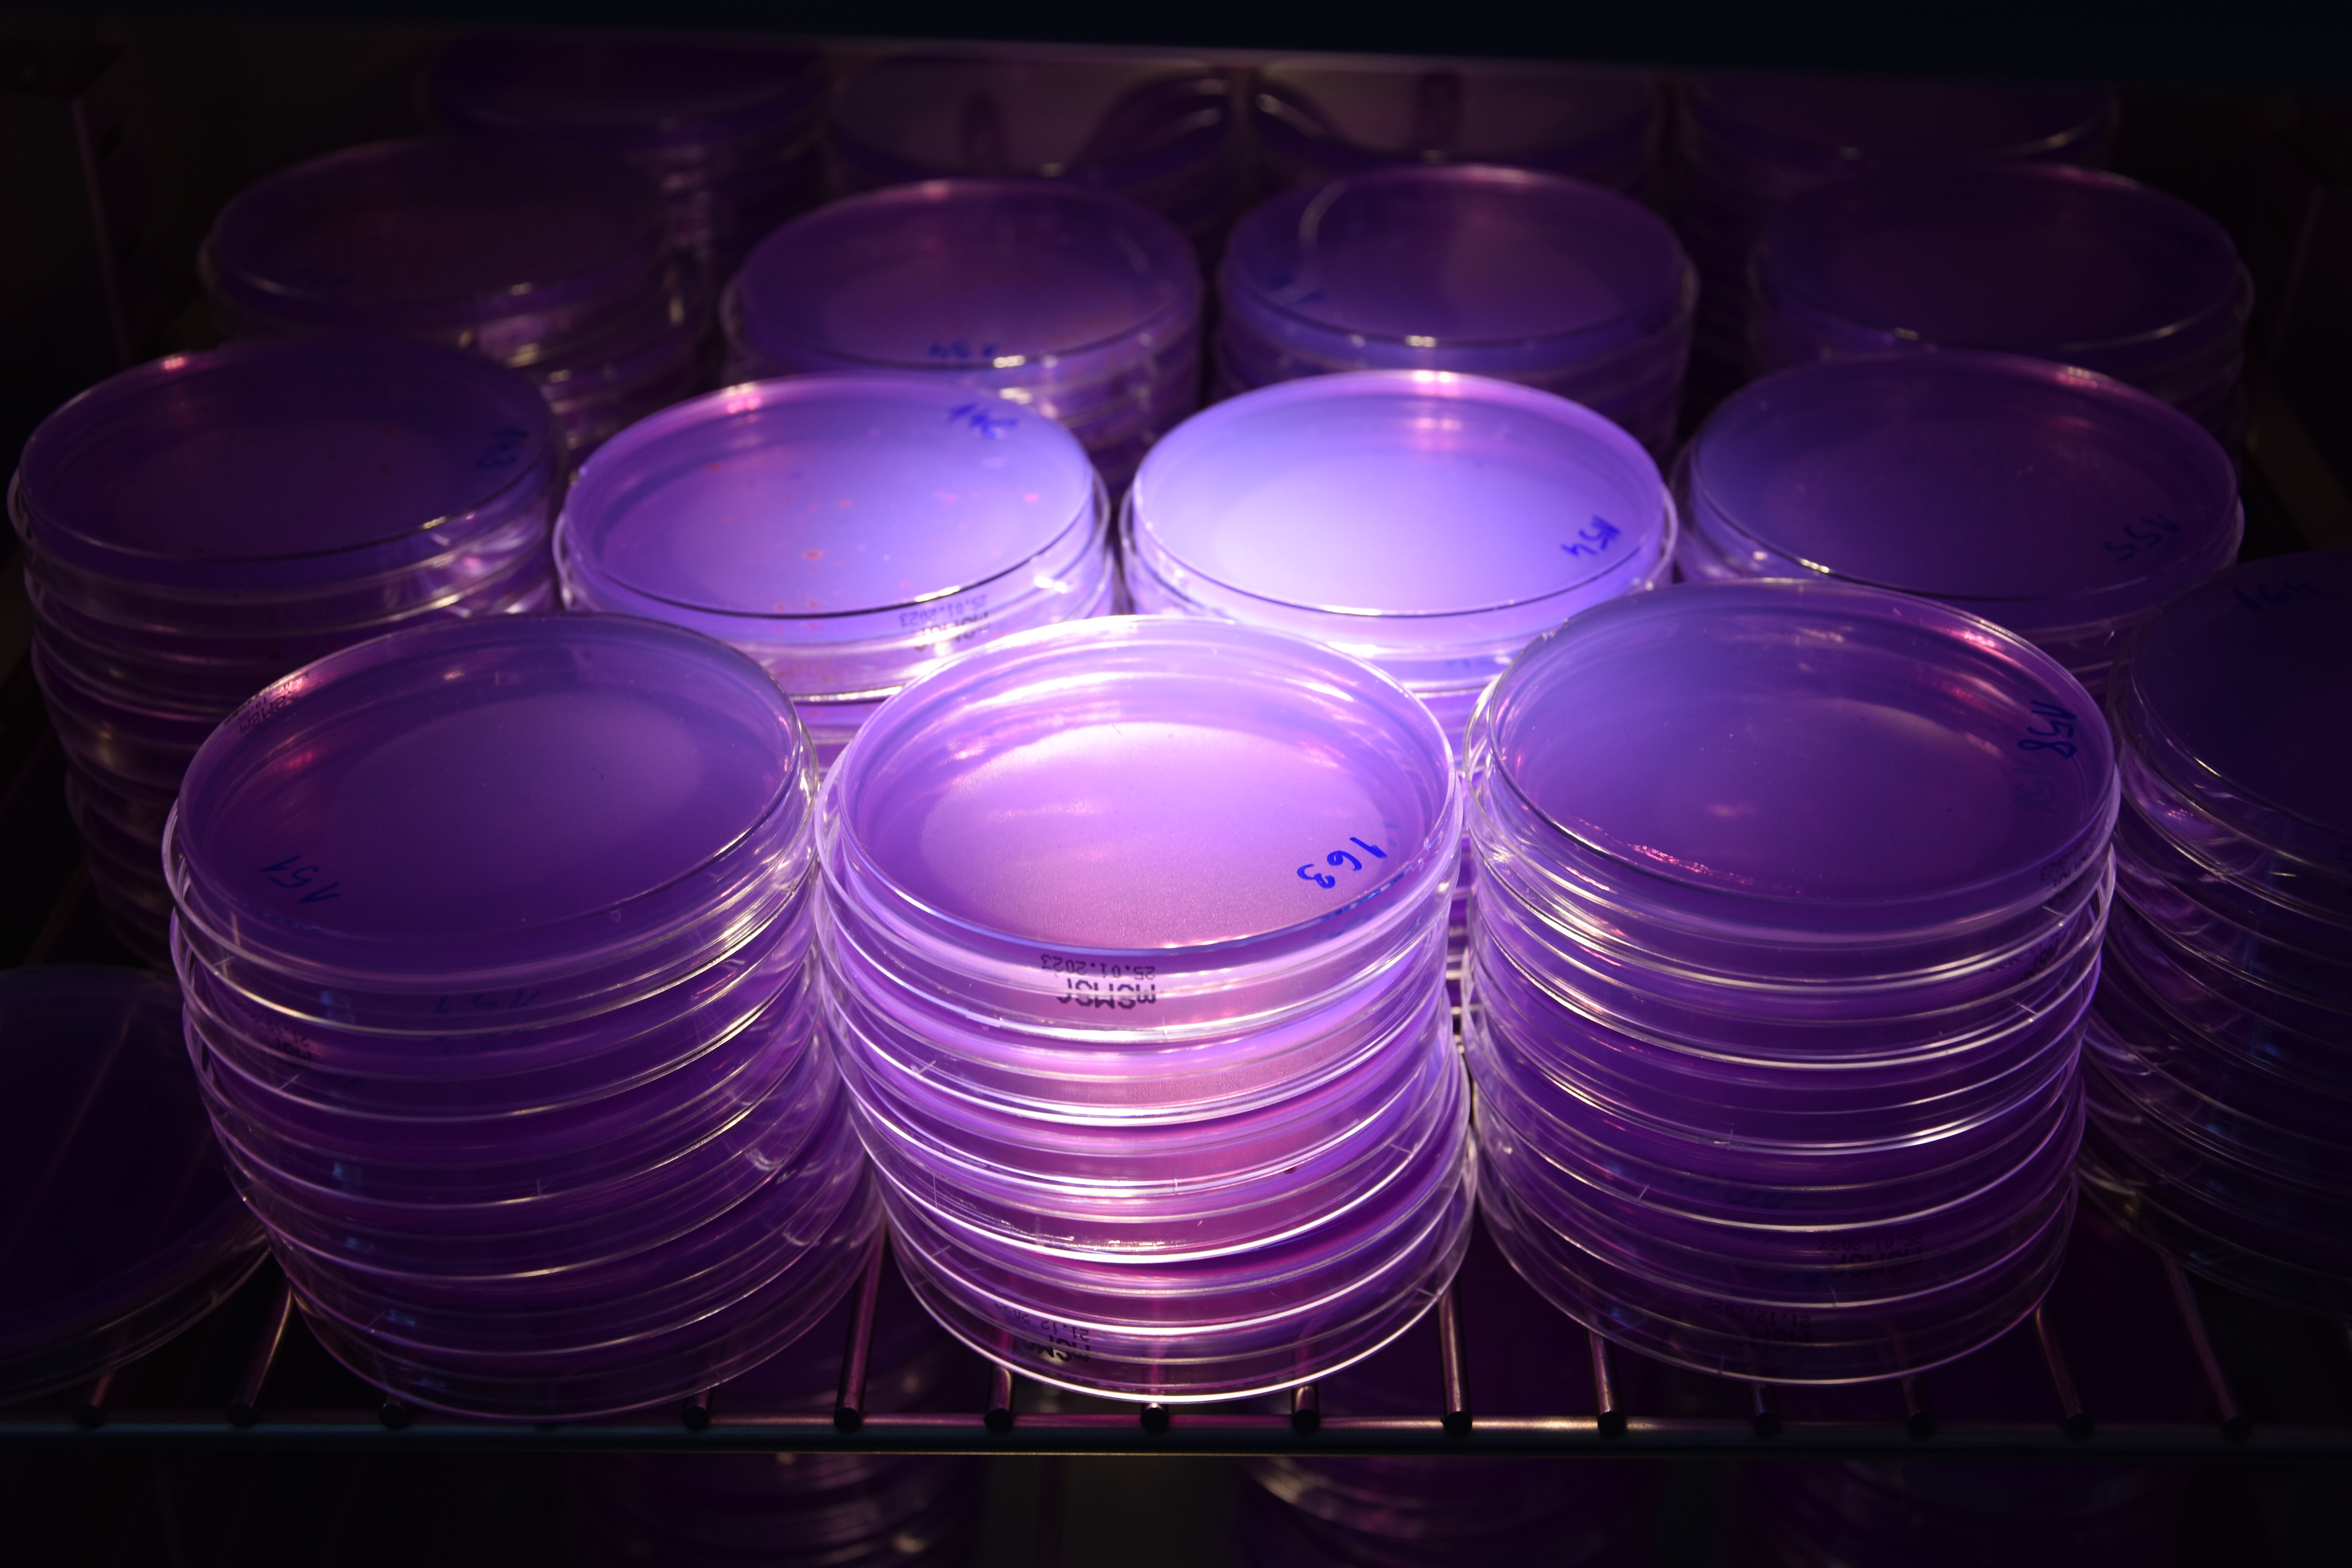

Referencyjne Laboratorium Fitosanitarne

O laboratorium
Referencyjne Laboratorium Fitosanitarne (RLF) zapewnia koordynację oraz nadzór nad działalnością Oddziałów Centralnego Laboratorium w zakresie diagnostyki bakterii, wirusów, wiroidów i fitoplazm, grzybów, nicieni i owadów szkodliwych dla roślin, objętych przepisami prawa. Sprawuje również nadzór metodyczny nad laboratoriami urzędowymi w zakresie prawidłowości wykonywania badań, którego element stanowią, organizowane przez RLF, badania biegłości i porównania międzylaboratoryjne. RLF stanowi zaplecze doradcze i dydaktyczne dla pracowników Inspekcji.
RLF jest odpowiedzialne za potwierdzanie pierwszych przypadków wykrycia agrofagów oraz weryfikację wyników w przypadku odwołań.
RLF jako krajowe laboratorium referencyjne, aktywnie współpracuje z Laboratoriami Referencyjnymi Unii Europejskiej we wszystkich obszarach swojej działalności diagnostycznej, uczestnicząc w szkoleniach, badaniach biegłości/porównaniach międzylaboratoryjnych organizowanych przez te instytucje.
Powyższe działania Referencyjnego Laboratorium Fitosanitarnego, mają na celu zapewnienie najwyższego poziomu świadczonych usług, a przede wszystkim rzetelności i wiarygodności wyników uzyskiwanych we wszystkich urzędowych laboratoriach fitosanitarnych.
Dane kontaktowe
Kierownik Laboratorium - Justyna Pięcińska
tel. 734 116 174
e-mail:
cl-tor@piorin.gov.pl
slab-tor@piorin.gov.pl
Adres:
ul. Żwirki i Wigury 73
87-100 Toruń
Godzinu urzędowania: 7:30 - 15:30
Pracownia Nematologii, Entomologii i Herbologii
Prowadzenie analiz laboratoryjnych roślin, produktów roślinnych i przedmiotów na obecność owadów i nicieni szkodliwych dla roślin.
tel. 56 639-11-15
tel. 56 639-11-16
Pracownia Wirusologii
Prowadzenie analiz laboratoryjnych roślin, produktów roślinnych i przedmiotów na obecność wirusów, wiroidów i fitoplazm szkodliwych dla roślin.
tel. 56 639-11-12
Pracownia Bakteriologii
Prowadzenie analiz laboratoryjnych roślin, produktów roślinnych i przedmiotów na obecność bakterii szkodliwych dla roślin.
tel. 56 639-11-13
Pracownia Mykologii
Prowadzenie analiz laboratoryjnych roślin, produktów roślinnych i przedmiotów na obecność grzybów i organizmów grzybopodobnych szkodliwych dla roślin.
tel. 56 639-11-14
Pracownia Biologii Molekularnej
Prowadzenie analiz laboratoryjnych roślin, produktów roślinnych i przedmiotów technikami biologii molekularnej.
tel. 56 639-11-10 wew. 29
tel. 56 639-11-15
Stanowisko ds. metodologii i analiz
tel. 56 639-11-10 wew. 31
Materiały
Zakres badań w RLFZakres_badań_RLF_wyd_34_20032026.pdf 0.88MB Zakres akredytacji RLF
RLF_Zakres_akredytacji_20052025.pdf 0.29MB Lista badań prowadzonych w ramach elastycznego zakresu akredytacji w RLF
Lista_badań_zakres_elastyczny_RLF_03_26.pdf 0.52MB Certyfikat akredytacji ISO17025 RLF
RLF_certyfikat_akredytacji.pdf 0.29MB